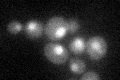
YDR279W

View description
Ribonuclease H2 subunit, required for RNase H2 activity; related to human AGS2 that causes Aicardi-Goutieres syndrome
Localization:
Intensity:
Fold change:
Significance:
-
C’ GFP library in SD
nucleus25.47 -
N' NOP1pr-GFP in SD

nucleus87.8428 -
N' TEF2pr-mCherry in SD

missing0 -
N' NATIVEpr-GFP in SD

nucleus24.653 -
N' TEF2pr-VC and Cyto-VN in SD

#N/A0 -
C’ GFP library in SD+DTT

nucleus180.7Yes -
C’ GFP library in SD+H2O2

nucleus21.520.84No -
C’ GFP library in Starvation Media

nucleus20.950.82No -
C’ GFP library on the background of Pup2-DaMP

nucleus -
C’ GFP library on the background of CCT mutant

nucleus25.02350.982271No
